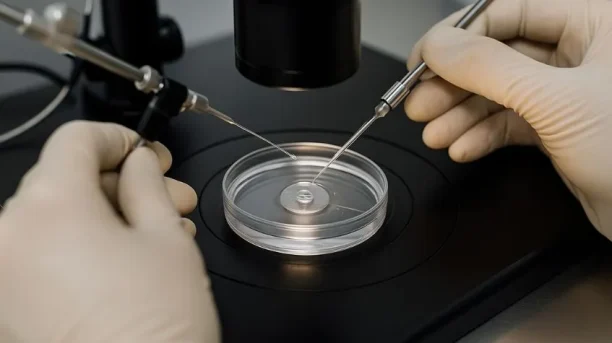

Capire le tecniche disponibili e cosa aspettarsi durante questo percorso può aiutare a vivere l’esperienza con maggiore consapevolezza e serenità.
Contenuti
Cos’è la fecondazione assistita?
La fecondazione assistita è un insieme di procedure mediche volte a favorire il concepimento nei casi in cui ci siano problemi di fertilità, sia maschile che femminile. Le tecniche possono variare in base alle esigenze della coppia e alla diagnosi medica.
Le principali tecniche di fecondazione assistita
Inseminazione artificiale (IUI)
Consiste nell’inserimento degli spermatozoi direttamente nell’utero durante l’ovulazione. La inseminazione artificiale è indicata per problemi di lieve entità, come una bassa motilità degli spermatozoi o difficoltà di ovulazione.
Fecondazione in vitro (IVF)
Nella fecondazione in vitro, nota anche come IVF o FIV, gli ovuli vengono prelevati dall’ovaio e fecondati in laboratorio con gli spermatozoi. Gli embrioni risultanti vengono poi trasferiti nell’utero. Questa tecnica di procreazione medicalmente assistita è indicata per problemi di infertilità più complessi, come ostruzioni tubariche o ridotta riserva ovarica.
ICSI (Iniezione intracitoplasmatica dello spermatozoo)
Una variante dell’IVF in cui uno spermatozoo viene iniettato direttamente nell’ovulo. Utilizzata in caso di grave infertilità maschile.
Tecniche avanzate di procreazione assistita
- FIVET con diagnosi genetica preimpianto (PGT): Consente di individuare eventuali anomalie genetiche negli embrioni prima del trasferimento.
- Donazione di ovuli o spermatozoi: Indicate per coppie in cui uno dei partner non produce gameti.
Cosa aspettarsi durante il percorso
Valutazione iniziale
Entrambi i partner saranno sottoposti a test medici per identificare le cause dell’infertilità e scegliere la tecnica più adatta.
Stimolazione ovarica
Nella maggior parte delle tecniche, la donna segue una terapia ormonale per stimolare la produzione di ovuli.
Può comportare controlli frequenti tramite ecografie e analisi del sangue.
Prelievo ovocitario e raccolta del seme
Gli ovuli vengono prelevati attraverso una procedura ambulatoriale.
Il partner maschile fornisce un campione di sperma.
Fecondazione e coltura degli embrioni
In laboratorio, gli ovuli e gli spermatozoi vengono combinati per creare embrioni.
Gli embrioni vengono monitorati per alcuni giorni prima del trasferimento.
Trasferimento degli embrioni
Gli embrioni più sani vengono trasferiti nell’utero tramite una procedura indolore.
Attesa dei risultati
Dopo il trasferimento, è necessario attendere circa due settimane per verificare l’impianto tramite un test di gravidanza.
Sfide emotive e come affrontarle
- Stress e ansia: Il percorso può essere emotivamente impegnativo. Parlate apertamente con il partner e, se necessario, rivolgetevi a un terapeuta.
- Sostegno reciproco: Affrontare insieme ogni fase aiuta a rafforzare il legame di coppia.
Consigli pratici
- Informarsi: Conoscere le procedure di gravidanza assistita aiuta a sentirsi più preparati e coinvolti nel percorso.
- Adottare uno stile di vita sano: Seguire una dieta equilibrata, evitare alcol e fumo e praticare attività fisica moderata può migliorare le probabilità di successo.
- Creare una rete di supporto: Condividere l’esperienza con amici fidati o partecipare a gruppi di supporto può alleviare il senso di isolamento.
Conclusione
Le tecniche di fecondazione assistita offrono speranza a molte coppie che desiderano diventare genitori. Sebbene il percorso possa essere impegnativo, affrontarlo con consapevolezza, supporto reciproco e una visione positiva può fare la differenza. Consultare specialisti e informarsi adeguatamente sono i primi passi verso il raggiungimento del proprio sogno di genitorialità.